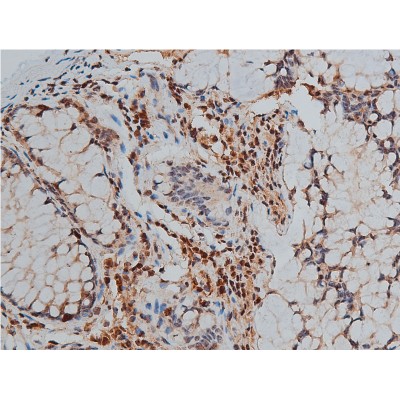
https://d1vffmuvmgkypt.cloudfront.net/image/ridacom_ltd/affinity_biosciences/PRODUCT_SOURCE__AFFINITY__SUPPLIER__RIDACOM__ID__AF3233__2

Antigen
GATA3
Isotype
IgG
(7)
IgG1
(1)
Reactivity
Human
(8)
Mouse
(7)
Rat
(2)
Clonality
Polyclonal
(7)
Monoclonal
(2)
Application
ELISA
(8)
Western Blotting
(7)
Immunofluorescence
(2)
Immunohistochemistry
(2)
IHC-P
(1)
Supplier
Affinity Biosciences
(5)
Abbkine Scientific Co., Ltd.
(3)
GenomeMe
(1)
Host
Rabbit
(7)
Mouse
(2)

Antigen:
Trans-acting T-cell-specific transcription factor GATA-3
Synonyms: GATA-binding factor 3; GATA3_HUMAN; P23771; Q5VWG7; Q5VWG8; Q96J16
Host:Rabbit
Reactivity:Human; Mouse
Application:Western Blotting; ELISA
Isotype:IgG
Clonality:Polyclonal
Aliases:GATA 3; GATA binding factor 3; GATA binding protein 3; GATA-binding factor 3; Gata3; GATA3_HUMAN; HDR; HDRS; MGC2346; MGC5199; MGC5445; Trans acting T cell specific transcription factor GATA 3; Trans-acting T-cell-specific transcription factor GATA-3
GATA3 Antibody
$280.00

Antigen:
Trans-acting T-cell-specific transcription factor GATA-3
Synonyms: GATA-binding factor 3; GATA3_HUMAN; P23771; Q5VWG7; Q5VWG8; Q96J16
Host:Rabbit
Reactivity:Human; Mouse; Rat
Application:Western Blotting; Immunohistochemistry; ELISA
Isotype:IgG
Clonality:Polyclonal
Aliases:GATA 3; GATA binding factor 3; GATA binding protein 3; GATA-binding factor 3; Gata3; GATA3_HUMAN; HDR; HDRS; MGC2346; MGC5199; MGC5445; Trans acting T cell specific transcription factor GATA 3; Trans-acting T-cell-specific transcription factor GATA-3; DCML; Endothelial transcription factor GATA 2; Endothelial transcription factor GATA-2; Endothelial transcription factor GATA2; FLJ45948; GATA 2; GATA binding protein 2; GATA-binding protein 2; Gata2; GATA2_HUMAN; IMD21; MGC2306; MONOMAC; NFE 1B; NFE1B; OTTHUMP00000216240

Antigen:
Trans-acting T-cell-specific transcription factor GATA-3
Synonyms: GATA-binding factor 3; GATA3_HUMAN; P23771; Q5VWG7; Q5VWG8; Q96J16
Host:Rabbit
Reactivity:Human; Mouse
Application:Western Blotting; ELISA
Isotype:IgG
Clonality:Polyclonal
Aliases:GATA 3; GATA binding factor 3; GATA binding protein 3; GATA-binding factor 3; Gata3; GATA3_HUMAN; HDR; HDRS; MGC2346; MGC5199; MGC5445; Trans acting T cell specific transcription factor GATA 3; Trans-acting T-cell-specific transcription factor GATA-3
| 50μl | $250.00 | |
| 100μl | $350.00 |
| 200μl | $450.00 |
GATA3 Antibody
$250.00

Antigen:
Trans-acting T-cell-specific transcription factor GATA-3
Synonyms: GATA-binding factor 3; GATA3_HUMAN; P23771; Q5VWG7; Q5VWG8; Q96J16
Host:Mouse
Reactivity:Human
Application:Western Blotting; Immunohistochemistry; ELISA
Isotype:IgG1
Clonality:Monoclonal
Aliases:GATA 3; GATA binding factor 3; GATA binding protein 3; GATA-binding factor 3; Gata3; GATA3_HUMAN; HDR; HDRS; MGC2346; MGC5199; MGC5445; Trans acting T cell specific transcription factor GATA 3; Trans-acting T-cell-specific transcription factor GATA-3
GATA3 Antibody
$250.00

Antigen:
Trans-acting T-cell-specific transcription factor GATA-3
Synonyms: GATA-binding factor 3; GATA3_HUMAN; P23771; Q5VWG7; Q5VWG8; Q96J16
Host:Rabbit
Reactivity:Human; Mouse
Application:Western Blotting; ELISA
Isotype:IgG
Clonality:Polyclonal
Aliases:GATA 3; GATA binding factor 3; GATA binding protein 3; GATA-binding factor 3; Gata3; GATA3_HUMAN; HDR; HDRS; MGC2346; MGC5199; MGC5445; Trans acting T cell specific transcription factor GATA 3; Trans-acting T-cell-specific transcription factor GATA-3
GATA3
$195.00

Antigen:
Trans-acting T-cell-specific transcription factor GATA-3
Synonyms: GATA-binding factor 3; GATA3_HUMAN; P23771; Q5VWG7; Q5VWG8; Q96J16
Host:Mouse
Clonality:Monoclonal
Positive control:Breast Carcinoma; Urothelial Carcinoma
Dilution range:1:100 - 1:200

Antigen:
Endothelial transcription factor GATA-2
Synonyms: GATA-binding protein 2; GATA2_HUMAN; D3DNB3; P23769; Q53YE0; Q96BH0; Q96BH8; Q9BUJ6
Trans-acting T-cell-specific transcription factor GATA-3Synonyms: GATA-binding factor 3; GATA3_HUMAN; P23771; Q5VWG7; Q5VWG8; Q96J16
Host:Rabbit
Reactivity:Human; Mouse; Rat
Application:Western Blotting; ELISA
Isotype:IgG
Clonality:Polyclonal

Antigen:
Trans-acting T-cell-specific transcription factor GATA-3
Synonyms: GATA-binding factor 3; GATA3_HUMAN; P23771; Q5VWG7; Q5VWG8; Q96J16
Host:Rabbit
Reactivity:Human; Mouse
Application:Immunofluorescence; ELISA
Isotype:IgG
Clonality:Polyclonal
GATA-2/3 Polyclonal Antibody
$100.00

Antigen:
Trans-acting T-cell-specific transcription factor GATA-3
Synonyms: GATA-binding factor 3; GATA3_HUMAN; P23771; Q5VWG7; Q5VWG8; Q96J16
Endothelial transcription factor GATA-2Synonyms: GATA-binding protein 2; GATA2_HUMAN; D3DNB3; P23769; Q53YE0; Q96BH0; Q96BH8; Q9BUJ6
Host:Rabbit
Reactivity:Human; Mouse
Application:Western Blotting; IHC-P; Immunofluorescence; ELISA
Isotype:IgG
Clonality:Polyclonal